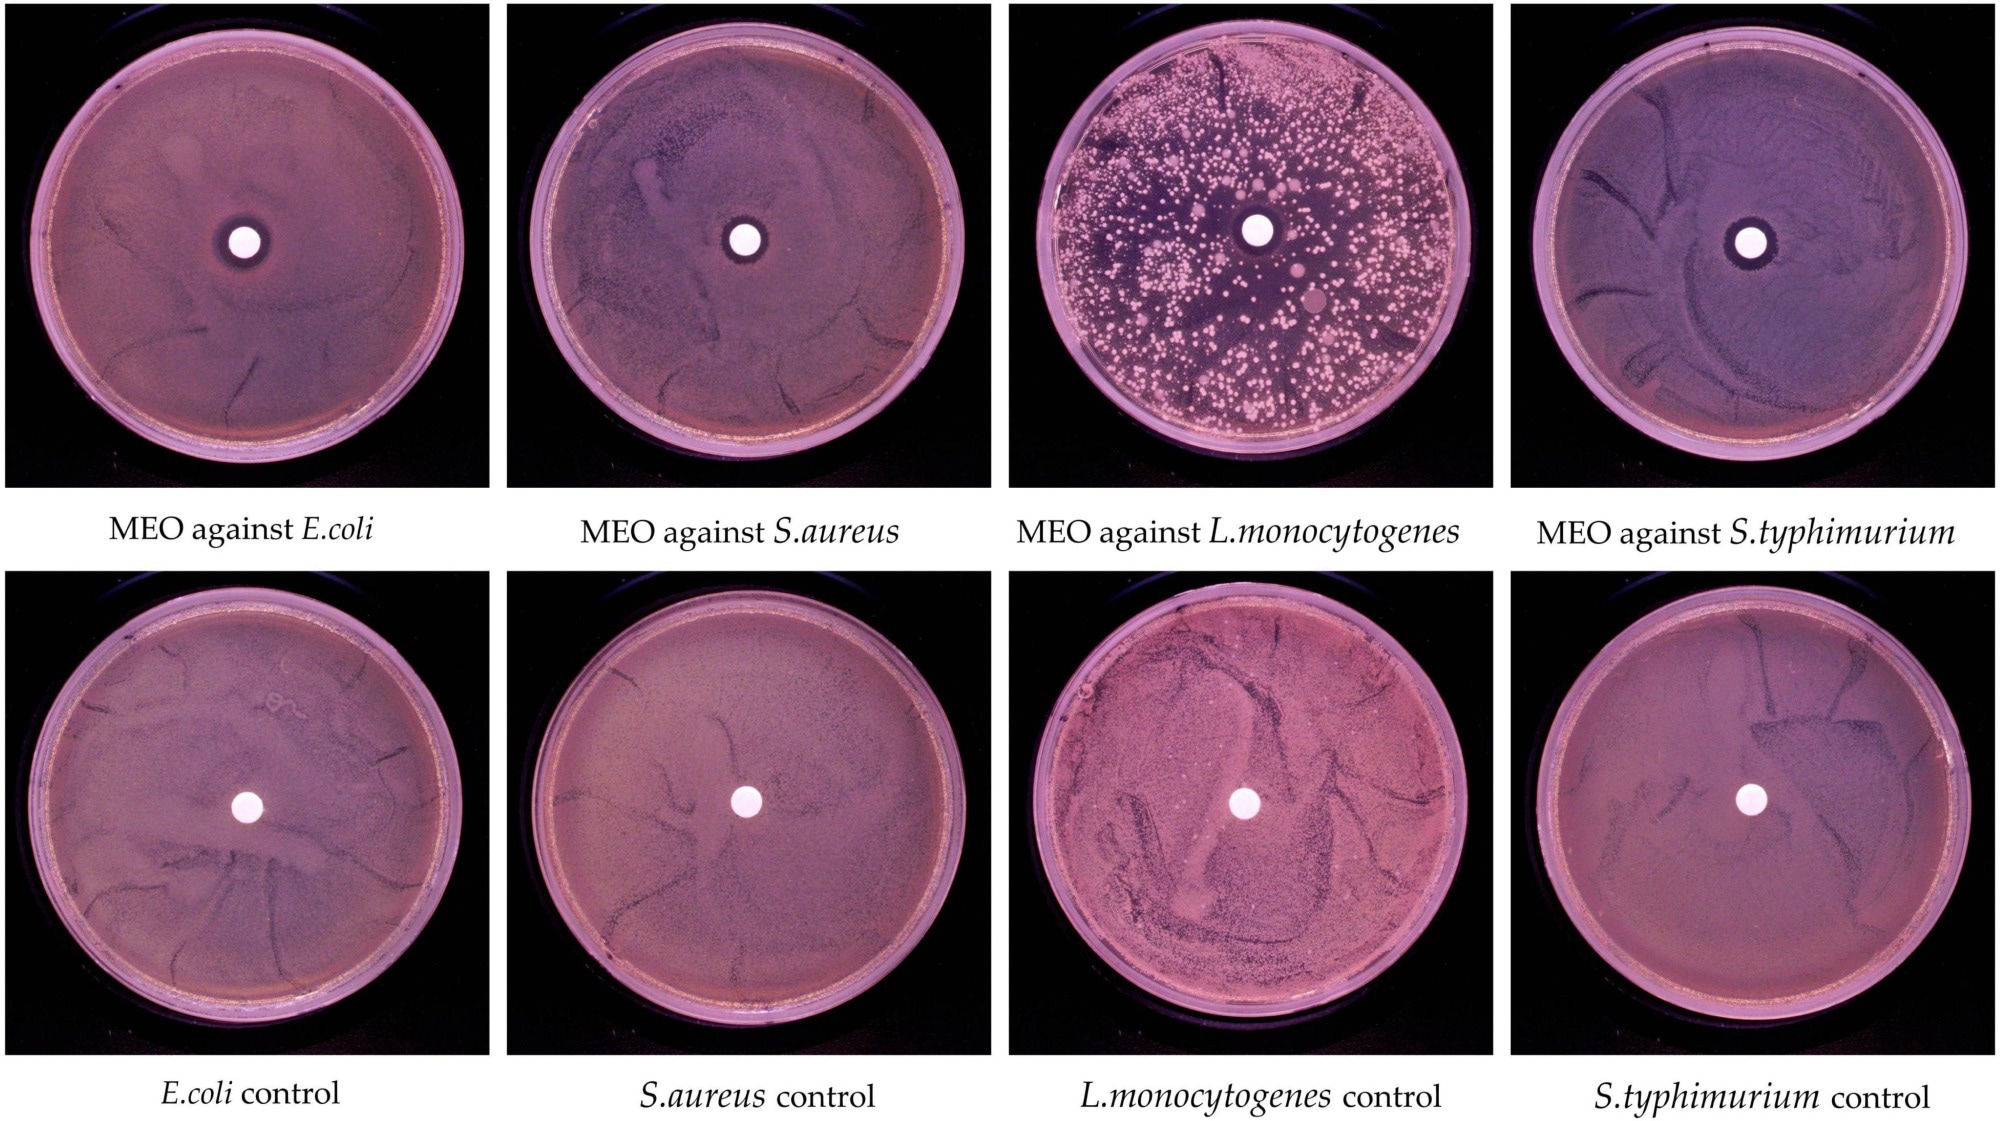

In lab tests, Magnolia essential oil disrupted harmful bacteria and neutralized free radicals, showing promise as a natural solution for food safety and antimicrobial packaging.
 Study: Magnolia essential oil: a preliminary exploration of chemical composition and its antimicrobial and antioxidant potential. Image Credit: Elena.Katkova / Shutterstock
Study: Magnolia essential oil: a preliminary exploration of chemical composition and its antimicrobial and antioxidant potential. Image Credit: Elena.Katkova / Shutterstock
In a recent study published in the journal Frontiers in Microbiology, researchers analyzed the chemical composition, antimicrobial, and antioxidant potential of Magnolia essential oil (MEO).
Natural essential oils derived from plants have long been recognized for their various biological activities, including antifungal, antioxidant, and antibacterial properties. Essential oils are mixtures of volatile compounds, such as phenols and terpenoids, that exhibit therapeutic properties. MEO is extracted from dried flower buds of Magnolia sprengeri, M. denudata, and M. biondii, and is rich in bioactive compounds like 1,8-cineole, linalool, and (+)-citronellal as major components, with eugenol and α-pinene also present in smaller amounts.
MEO has anti-inflammatory, antioxidant, and antibacterial properties, and it has been used in the food industry to inhibit foodborne pathogens and delay spoilage. However, research on the antibacterial mechanisms of MEO and its interactions with bacterial metabolism is limited. Therefore, a better understanding of these mechanisms could lead to the development of novel antimicrobial agents from MEO.
About the Study
In the present study, researchers analyzed MEO's chemical composition, as well as its antioxidant and antimicrobial potential. First, they performed gas chromatography-mass spectrometry (GC-MS) analysis to determine MEO's chemical composition. The National Institute of Standards and Technology (NIST) database was used to identify compounds in MEO.
The area normalization method was applied to estimate the relative content of compounds in the chromatogram. The filter paper disk diffusion method was used to evaluate the antibacterial activity of MEO against the common foodborne pathogens: Salmonella typhimurium, Listeria monocytogenes, Staphylococcus aureus, and Escherichia coli.
The microdilution method was used to assess the minimum inhibitory (MIC) and bactericidal (MBC) concentrations of MEO. MEO’s effects on the growth curve of test bacteria were also evaluated. The team used ultraviolet spectrophotometry to measure the release of intracellular substances following MEO treatment. Additionally, the electrical conductivity of bacterial cultures after MEO incubation was measured using a conductivity meter.
Biochemical assays were performed to determine the activity of intracellular enzymes such as superoxide dismutase (SOD), malondialdehyde (MDA), ATPase, and alkaline phosphatase (AKP). Bacteria were examined using scanning electron microscopy (SEM). Further, the antioxidant activity of MEO was determined using the DPPH scavenging, FRAP, and hydroxyl radical scavenging assays.
Findings
GC-MS analysis identified 49 compounds in MEO, representing 99.04% of the total MEO content. The primary constituents were terpenoids. 1,8-cineole, linalool, and (+)-citronellal were the major components, accounting for 44.8%, 29.1%, and 6.9% of MEO, respectively. MEO inhibited the growth of all tested pathogens, with inhibition zones ranging from 10.9 mm to 12.6 mm. MEO had an MIC of 4 μl/ml against S. typhimurium and L. monocytogenes and 5 μl/ml against S. aureus and E. coli.
In vitro antibacterial activity of magnolia essential oil (MEO).
In vitro antibacterial activity of magnolia essential oil (MEO).
The MBC of MEO was 5 μl/ml for E. coli, S. typhimurium, and L. monocytogenes and 8 μl/ml for S. aureus, indicating weaker bactericidal activity against S. aureus. Treatment with MEO at 0.25 MIC and 0.5 MIC effectively delayed the logarithmic growth phase of all tested bacteria. Bacterial incubation with MEO increased extracellular protein and nucleic acid content, suggesting that MEO disrupts cell membrane permeability, leaking intracellular contents.
Moreover, incubation with MEO increased the electrical conductivity of bacterial cultures due to the release of intracellular contents that carry electrical charges. Incubation with MEO significantly reduced AKP and ATPase levels in all four pathogens. In contrast, MDA and SOD levels were significantly elevated following MEO treatment.
SEM revealed collapsed bacterial cell surfaces, ruptures, indentations, and distorted shapes in all four bacteria treated with MEO, suggesting that MEO damages bacterial membranes and cell wall structures. MEO had the highest scavenging activity against DPPH radicals, followed by hydroxyl radicals, and showed a dose-dependent antioxidant response.
While these results demonstrate strong antimicrobial and antioxidant properties, the authors note several challenges and limitations before MEO can be widely applied. Essential oils, such as MEO, are highly volatile and may degrade when exposed to heat, light, or oxygen. Their strong aroma and hydrophobic nature may limit their direct application in certain foods, and the potential cytotoxicity of MEO at higher concentrations requires further evaluation to ensure consumer safety. The study suggests that future research should focus on improving the stability and controlled release of MEO, for example, through nanoencapsulation, and on assessing its safety for long-term use.
Conclusions
The findings illustrate the antibacterial activity of MEO against S. typhimurium, S. aureus, E. coli, and L. monocytogenes. The antibacterial potency of MEO was comparable to or higher than that of previously reported essential oils. MEO delayed the bacterial logarithmic growth phase, caused leakage of intracellular materials, and induced oxidative stress, impairing bacterial metabolism and survival. MEO also had robust antioxidant properties, indicating potential for broader applications. However, addressing the challenges related to stability, aroma, and safety is necessary for future commercial or food industry use.